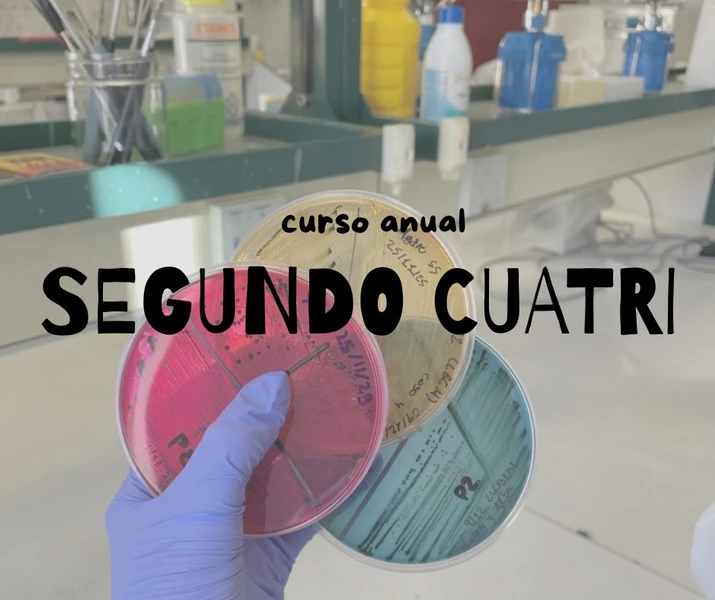
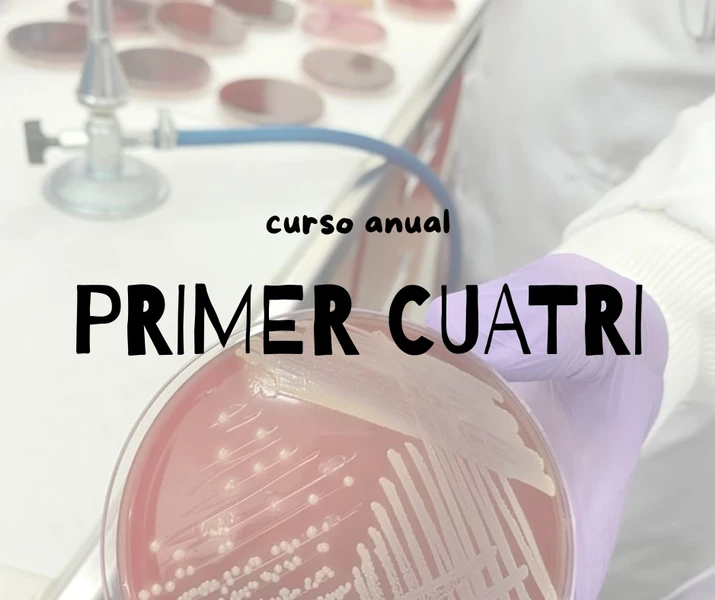

MICROBICHERIO
Micro no es imposible… si sabés cómo estudiarla.
Si buscas que alguien te acompañe, te guíe y te facilite el estudio, ya sea para la cursada, los parciales o el final, este curso es para vos.

¿Estás preparando parciales o finales?
Contamos con cursos anuales e intensivos pre parcial y de final. Accedé a clases grabadas, material de estudio, preguntas de repaso y múltiples choice para que puedas aprender de forma ordenada, clara y a tu ritmo. No dejes que los bichos te ganen, estudiá con nosotros y transformá la microbiología en tu materia favorita
Nuestros Cursos
Testimonios de nuestros alumnos
Te mandaba para comentarte que al final el examen lo rendí el 1/12 y APROBÉ! Lo imaginaba tan imposible y ahora es una realidad, un recuerdo...
Te quería agradecer por el curso, por la guía hacia donde apuntar y enseñarme a estudiar esta materia! Exitosss ✨✨
Aylen M.
Quería avisarte que aprobé el final de micro, fue la 1 vez que rendí.
Rendí el escrito y aprobé, después rendí el oral. Cuando aprobé no lo pude creer venía pateando el final hace tiempo por miedo, y gracias a dios aprobé en la primera tentativa. Quería agradecer mucho, porque su material fue fundamental, mi ayudó a organizar mucho la materia
Carol D.
Dani soy una de tus alumnas,aprobé micro, por eso quería escribirte para agradecerte. Por el curso me ha ayudado muchísimo
Anto
Hola Dani! Cómo estás? Te cuento que acabo de salir del oral de micro. Por suerte aprobé. Hoy tomaron escrito y oral. Después armo un testi y te lo mando. Pero te quería súper agradecer! Me ayudó muchísimo todo lo del curso!💗💗
Rocio P.